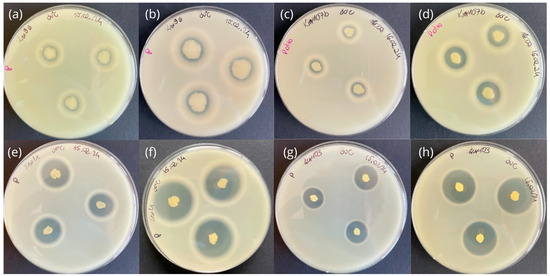

Abstract
The volume of difficult-to-process keratin waste is increasing as a result of rising global meat production. If not properly managed, this waste can contribute to environmental pollution and pose a threat to human and animal welfare. An interesting and more sustainable alternative is therefore the bioconversion of keratin using microorganisms and their enzymes. This work aimed to isolate bacteria from soil samples and zoonotic keratins and to evaluate their enzymatic capacity to degrade α- and β-keratin wastes. A total of 113 bacterial strains were isolated from environmental samples and subjected to taxonomic identification using the MALDI-TOF MS technique and to a two-step screening for proteolytic and keratinolytic activity. The ability to degrade a β-rich keratin substrate was observed in almost all of the strains isolated from soil and horsehairs. In contrast, when an α-rich keratin substrate was used, the highest levels of hydrolysis were observed only for Ker39, Ker66, Ker85, Ker100, and Ker101. Strains with the highest biodegradation potential were identified using molecular biology methods. Phylogenetic analysis of 16S rDNA gene sequences allowed the assignment of selected keratinolytic microorganisms to the genera Exiguobacterium, Priestia, Curtobacterium, Stenotrophomonas, Bacillus, Kocuria, or Pseudomonas. The results of this study are a promising precursor for the development of new, more sustainable methods of managing keratin waste to produce high-value hydrolysates.
1. Introduction
Human civilization, with its numerous activities, results in the accumulation of a vast amount of solid waste in the environment. One of the fastest-growing types of waste is keratinous materials, estimated to be several million tonnes per year [1]. Keratins are primarily derived from animal body parts and serve as waste byproducts of industrial processes, mainly from slaughterhouses, poultry farms, and leather industries [2]. If not managed properly, keratin waste can significantly impact ecosystems, contributing to environmental pollution, and pose serious hazards to human and livestock health [3].
Keratins constitute a heterogeneous family of proteins and are the third most abundant biomass in nature, after chitin and cellulose. This polymer forms solid structures, held together by disulfide bonds formed between the thiol groups (–SH) of cysteine amino acid residues, as well as hydrogen bonds and hydrophobic interactions [4]. They are characterized based on their secondary structures (mainly α-helices and β-sheets), sulfur content (soft and hard), amino acid composition (basic, acidic, or neutral), molecular weight, and source of origin [5]. The multi-level structure and high number of cross-linkages between various types of keratins result in a high resistance to mechanical, chemical, and physical factors [6]. These hard-to-degrade proteins are mostly disposed of through landfilling or incineration, which is ecologically disadvantageous due to the apparent energy loss and the production of large amounts of carbon dioxide [7]. The most promising alternatives to these techniques are biotechnological methods using keratinolytic microorganisms or more controlled hydrolysis with cell-free keratinase extracts and purified keratinases [8]. The complex and recalcitrant structure of keratin requires synergistic interactions of different types of keratinolytic enzymes to be effectively decomposed.
Keratinases (E.C. 3.4.21) are extracellular enzymes capable of degrading keratin [9]. They are produced by microorganisms, including bacteria, and filamentous fungi, including dermatophytic species. The main industrial producers of keratinases are strains belonging to the genus Bacillus (e.g., B. cereus, B. subtilis, B. pumilus, B. stearothermophilus, B. licheniformis, B. coagulans). Other promising producers include Gram-positive bacteria such as Lysobacter, Nesternokia, Kocuria, Microbacterium, and Streptomyces and some Gram-negative bacteria, e.g., Xanthomonas, Aeromonas, Stenotrophomonas, Serratia, Chryseobacterium, and Vibrio [8,10,11,12]. Keratinolytic proteases have also been isolated from extremophilic microorganisms, including representatives such as Pseudoalteromonas, Colwellia, Flavobacterium, Shewanella, Fervidobacterium, Thermoanaerobacter, and Nesternokia [8,9].
The industry has a keen interest in microorganisms capable of producing large amounts of efficient extracellular keratinases. However, the utility of these enzymes is currently underexploited due to the limited availability of keratinolytic protease producers. Isolating novel strains that produce significant yields of well-performing enzymes with versatile substrate specificity, increased stability at elevated temperatures and/or pH values, and higher tolerance to feedback inhibition is essential for the development of a viable industrial fermentation [9,13].
In this study, keratinolytic bacteria were isolated from soil and horsehair samples. This report describes the identification of these bacteria based on MALDI-TOF MS and the molecular 16S rDNA method. The studies also determined the abilities of microorganisms to hydrolyze casein and keratin waste substrates, such as chicken feathers (CHFs), horsehair (HH), and dog hair (DH). The highest keratinolytic activity was observed in Exiguobacterium, Bacillus and Kocuria genera. Strains isolated within this research, thanks to their enzymatic abilities, can be regarded as innovative and environmentally friendly tools with potential application in the rational management of keratin waste and associated technologies. Such strategies are in line with the principles of green chemistry and a circular economy.
2. Results
2.1. Isolation and Preliminary Identification of Microorganisms
Bacterial colonies were isolated from environmental samples (Table 1) during cultivation on an LB medium in various temperatures (10 °C, 20 °C, and 30 °C).

Table 1.
Environmental samples used for the isolation of microorganisms with keratinolytic potential.
The total number represented 113 bacterial strains: 55 isolated from horsehair samples and 58 from soil. In the presented research, the highest numbers of bacterial strains were obtained from winter coat sample KGMa (23 strains), greenhouse soil samples GB1 and GC1 (15 and 11 strains, respectively), and fetlock horsehair sample KPMa (also 11 strains). While soil samples are commonly used to isolate new microbial strains, horsehair microbiome studies tend to focus on identifying pathogens in sick animals for veterinary purposes, because the isolates are tested almost exclusively for antibiotic resistance [14]. Studies focusing on other properties of microorganisms isolated from horses are quite rare. The highest number of strains was isolated at 30 °C and consisted of 76 isolates. Significantly lower numbers of isolates were obtained at 20 °C and 10 °C, which were 29 and 8 isolates, respectively (Figure 1). The further testing of strains was carried out at the temperatures of their isolation.

Figure 1.
Temperature- and isolation-site-dependent number of isolated strains. Horsehair (KGHa, KGMa, KPH, KPMa, KSHa, KSMa) and soil samples (GA1, GA2, GB1, GB2, GC1, GC2).
All isolated strains were subjected to preliminary taxonomic identification using matrix-assisted laser desorption/ionization time-of-flight mass spectrometry (MALDI-TOF MS). The MALDI-TOF protein mass fingerprinting was implemented in this research as a relatively fast and cost-effective technique, gaining more recognition in the field of microbial identification [15,16,17]. The results obtained in this step are available in Supplementary Table S1. Only strains with MALDI identification (ID) score ≥ 70% were regarded as sufficient and used for the generation of biodiversity plots (Figure 2).

Figure 2.
The biodiversity of strains isolated from horsehair (KGHa, KGMa, KPH, KPMa, KSHa, KSMa) and soil samples (GA1, GA2, GB1, GB2, GC1, GC2). The isolates were identified using matrix-assisted laser desorption/ionization time-of-flight mass spectrometry (MALDI-TOF MS). Only identification scores ≥ 70% were regarded as sufficient and used for biodiversity plots.
Identified bacteria were representatives of classes Bacilli (44 strains), Gammaproteobacteria (11 strains), and Actinomycetes (1 strain). The majority (86%) of Bacilli class isolates belonged to the genus Bacillus—common constituent of animal, plant, water, and soil microbiomes, similarly to the identified Aeromonas (5 strains) [18], Kocuria (1 strain) [19], Serratia (1 strain) [20], Pseudomonas (2 strains) [21], and Priestia (2 strains) isolates [22]. Moreover, many isolated strains, belonging to the Pseudomonas, Staphylococcus and Acinetobacter genera, have been previously recognized as part of a healthy and wound-related horse microbiome [23,24,25]. Bacteria from Bacillus, Priestia, Kocuria and Pseudomonas genera have already been associated with positive ecological roles, including the development of soil fertility [26,27], nitrogen fixation [28], the bioremediation of hydrocarbon compounds and heavy metals [19,29], and animal and plant health and growth promotion [28,30,31,32]. However, as with many representatives of Aeromonas, Staphylococcus, and Serratia [33], some of the Bacillus and Pseudomonas species are also known as pathogenic and opportunistic microorganisms [34,35]. Of all isolated bacterial strains, almost 51% (57 strains) were not identified with the chosen preliminary method. This can be the result of the high diversity of environmental isolates and significant differences in their proteomic makeup in comparison to reference (often collection or clinical) strains, typically used for the development of MALDI-TOF databases [36,37]. To increase the efficiency and reliability of MALDI-TOF MS identification, different methods or more specific, custom-made databases could be used or developed [16,37,38,39].
2.2. Evaluation of Proteolytic Activity of Isolated Strains
In the search for strains exhibiting keratinolytic activity, cultivation on a medium enriched with skimmed milk is a well-established method of primary selection [40,41,42,43]. Most of the identified keratinase producers also show the ability to hydrolyze simple protein substrates, including casein [44,45,46]. This strategy was also implemented in the present study. A screening test on agar plates containing skimmed milk was conducted, and the enzymatic activity index (EAI) values were calculated. A total of 106 out of 113 isolates were observed to exhibit proteolytic activity after 48 h of cultivation (Figure 3). Only for seven strains were clear zones around colonies not observed, including six horsehair isolates and one soil isolate.
Figure 3.
Selected strains exhibiting proteolytic activity on LB agar medium supplemented with skimmed milk after 24 h and 48 h of incubation at 30 °C. Ker96 showed low proteolytic activity after (a) 24 h (EAI = 0.19) and (b) 48 h (EAI = 0.26). Ker107b exhibited medium proteolytic activity after (c) 24 h (EAI = 0.65) and (d) 48 h (EAI = 1.10). Ker11 revealed high proteolytic activity after (e) 24 h (EAI = 1.94) and (f) 48 h (EAI = 2.50). Strain Ker103 also demonstrated high proteolytic activity within (g) 24 h (EAI = 1.87) and (h) 48 h (EAI = 2.94).
A predominant majority (~98%) of the soil-derived isolates showed some degree of proteolytic activity. The ability to produce soil proteases is characteristic not only for pathogenic microorganisms, but also for typical destruents living in such environments [47]. Proteases of microbial origin are the most abundant among proteolytic enzymes in the soil [48]. Due to their unique kinetic properties and responses to environmental factors in different ecosystems, proteases are considered important in protein mineralization processes, resulting in an improvement in soil properties [47,49]. In many ecosystems, proteolysis plays a crucial role in nitrogen cycling by converting nitrogen from large biopolymers into a simpler form, which is more accessible for microbial and plant uptake [49]. Microbial proteases are also involved in carbon cycling, which is likely to be their primary function. Around 85–90% of all organic carbon decomposition is attributed to microorganisms living in the soil, making them an inherent part of most ecosystems [50]. Furthermore, protease production by microbes is essential for multispecies interactions, including symbiotic and antagonistic behaviors [51,52,53].
Among the isolated strains, approximately 94% exhibited the ability to synthesize peptidases of varying activity (Figure 4). The highest proteolytic activity, exceeding EAI = 1.8, was observed for ten isolates: seven corresponded to horse-related samples (Ker2, Ker4, Ker7, Ker10a, Ker12, Ker25, Ker48) and three to soil samples (Ker68, Ker97, Ker103). Seven strains, Ker9c, Ker10b, Ker14, Ker24, Ker26, Ker35, and Ker98, were regarded as non-proteolytic (EAI = 0 after 48 h at given temperature; Supplementary Table S1). However, they might exhibit such activity after a longer incubation time or when cultured with proteinaceous substrates other than casein (present in skimmed milk), e.g., albumin, gelatine, fibrin, elastin, and collagen [54,55]. This might be connected to various substrate specificities of known keratinolytic enzymes [56]. Therefore, in the next stage of this research, all isolated strains were tested for keratinolytic activity by submerged cultivation with keratin waste substrates.

Figure 4.
Proteolytic activity of isolated bacterial strains (A) with total number of active strains (EAI > 0) (B). The proteolytic activity was measured by the translucence around grown bacterial colonies on agar plates containing skimmed milk and expressed as enzymatic activity index (EAI) after 48 h of incubation.
2.3. Evaluation of Keratinolytic Aptitude in the Degradation of Waste Substrates
The second stage of screening involved the cultivation of isolated strains on media containing keratin substrates, such as chicken feathers (CHFs), horsehair (HH), and dog hair (DH). After seven days of incubation (140 rpm at 10 °C, 20 °C, or 30 °C), 16 of the 113 isolates were regarded as incapable of hydrolyzing any of the used substrates (85.8% active strains) (Figure 5). In the case of DH decomposition, a semi-positive result was obtained for four isolates derived from soil (Ker75, Ker76, Ker79, Ker81), for which we only observed a higher turbidity of the culture medium. The remaining strains showed no ability to hydrolyze this substrate. Significantly, 84% of the tested strains were able to degrade the β–keratin substrate (CHFs). Most of those strains were soil bacteria. With HH as the carbon source, the only macroscopic changes that were observed were hair fragmentation, as well as a change in the color and turbidity of post-culture liquid. Complete degradation of this α-keratin-rich substrate was not observed for any strain.

Figure 5.
Keratinolytic activity of isolated strains on two different substrates (chicken feathers and horsehair) (A). The ability to degrade α- and β-rich keratin substrate was measured macroscopically, scaled from 0 to 3 (B).
There is a noticeable difference between isolates derived from soil and horsehair samples. The latter are mostly unable to degrade horsehair. This can correlate significantly with their origin, as healthy animal microbiota should not exhibit substantial keratinolytic abilities towards host organisms and can be related to inhibitory effects of the metabolism of the host organism and its cutaneous microbiota on the growth and spread of potentially pathogenic microorganisms utilizing proteases and keratinases as virulence factors. The only exception was strain Ker39, which was revealed to possess a higher ability to degrade horsehair than other horse-derived isolates. In contrast, most of the soil isolates were able to degrade this α-keratin-rich HH substrate to various extents. Moreover, Ker66, Ker71, Ker85, and Ker101 strains were able to catalyze the hydrolysis of both α- and β-rich keratin substrates (HH and CHFs, respectively). Of all 113, only 15 isolates did not exhibit a keratinolytic potential in response to any substrate under tested conditions, six of which did not possess observable proteolytic activity during cultivation on agar test plates with skimmed milk (see Section 2.2). Furthermore, two isolates Ker39 and Ker41 with low proteolytic activity (not exceeding EAI = 0.09) exhibited keratinolytic activity towards at least one keratin waste substrate. Strain Ker39 had high and medium activities towards CHFs and HH, respectively, and strain Ker41 had a medium activity towards CHFs. Interestingly, even though clear zones around colonies of isolate Ker24 were not observed when cultivated on skimmed milk agar, the strain showed the ability to hydrolyze CHFs. This indicates that the skimmed milk agar plate test, though commonly used, might not always allow for the elimination of non-keratinolytic strains in the preliminary screening stages.
This may be related to non-optimal test conditions for the sought-after enzymatic activity or with different molecular mechanisms of keratin degradation, based on the presence and cooperation of enzymes from various families and classes [44,57,58] with their substrate specificity determining the efficiency of degradation of waste keratins. In future studies, the effect of temperature, pH, time of incubation, specificity towards other keratin-rich substrates, or the role of substrate form (e.g., the size of the pieces used) could be further examined. Although the biochemical activity can vary greatly between keratinases, typically temperatures between 40 and 60 °C and neutral or alkaline pH (7–10) are considered optimal [59]. The changes in medium composition during the biodegradation process could also influence its kinetics. A study of several Aphanoascus keratinophilus strains suggests the presence of a weak correlation between the accumulation of the liberated ammonia in the medium and the inhibition of fungal keratinases after 3 weeks of culturing [60]. The above indicates that monitoring of the carbon-to-nitrogen ratio throughout the keratin degradation process might improve its effectiveness.
Based on the results from screening on proteolytic and keratinolytic activity followed by MALDI-TOF, 29 strains, 8 of which were from horsehair samples and 21 were from soil samples, were selected for molecular taxonomic identification as potential producers of keratinolytic enzymes with 16S rDNA sequencing.
2.4. Molecular Identification and Phylogenetic Analysis of Selected Strains
Molecular identification based on sequencing of the 16S rDNA fragment was performed to accurately confirm the taxonomic affiliation of the selected 29 bacterial strains (Supplementary Table S2). The horse isolates with keratolytic potential belonged to genera Exiguobacterium, Mammalicoccus (formerly Staphylococcus), Curtobacterium, and Priestia. Among the soil isolates, 12 corresponded to the genus Bacillus and the remaining were classified as Pseudomonas, Areomonas, Kocuria, and Stenotrophomonas. Molecular identification confirmed the results obtained with MALDI-TOF MS. Even though 21 isolates were not identified by mass spectrometry (MALDI ID score lower than 70%), some strains, such as Stenotrophomonas Ker107b, Pseudomonas Ker87, and Bacillus Ker85, were classified correctly on the genus level and later confirmed by 16S rDNA sequencing. Moreover, none of the strains were misidentified. The microbial collection acquired during this study will enrich the in-house database of mass spectra of the keratinolytic strain, enabling the more accurate and efficient identification of related strains in the future. While marker gene sequencing remains the golden standard of taxonomic classification, both methods cannot be regarded as highly reliable for species-level identification without additional biochemical or bioinformatic analyses, as many close-related bacteria generate almost identical MALDI-TOF spectra and possess highly similar 16S rDNA sequences, especially in the Bacillus genus [39,61].
Phylogenetic analyses showed that all newly identified strains are phylogenetically related to the other known species of the respective genus (Figure 6 and Figure 7). The Curtobacterium sp. Ker43 isolated in this study, which is closely related to Curtobacterium allii, was the first strain with keratinolytic potential from this genus identified to date. This is in contrast to strains Mammaliicoccus sp. Ker33, Priestia sp. Ker37, and all new isolates that belong to genus Exiguobacterium, for which numerous literature reports indicate their keratinolytic activity. It was shown that strains of the genus Exiguobcterium isolated from soil samples, such as Exiguobacterium sp. DG1 [62] and Exiguobacterium indicum AKAL11 [63], were able to degrade chicken feather. None of the isolated strains belonging to this genus were closely related to keratinolytic strains described in earlier research.

Figure 6.
Phylogenetic analysis of strains isolated from horsehair. Phylogenetic analyses were performed in the MEGA-X program using the maximum likelihood (ML) method. Bootstraps analyses were performed using ultrafast bootstrap approximation with 1000 replicates.

Figure 7.
Phylogenetic analysis of strains isolated from soil. Phylogenetic analyses were performed in the MEGA-X program, using the maximum likelihood (ML) method. Bootstraps analyses were performed using ultrafast bootstrap approximation with 1000 replicates.
Phylogenetic analysis of the strains of the genus Bacillus has shown that they are mostly members of the Bacillus cereus group (Figure 7). Only one strain, Ker79, is closely related to B. licheniformis, B. subtilis, and B. amyloliquefaciens, which are some of the best known and studied keratinolytic bacteria. The distinctiveness of the Bacillus cereus group from Bacillus cluster was previously demonstrated [61]. Bacteria of the genus Bacillus constitute a substantial group among all keratinase-producing bacteria with many strains for which high keratinolytic activity has been proven [64,65,66,67,68].
Keratinolytic activity has been previously described in strains of the genus Kocuria [69,70], with one representative being Kocuria rosea LPB-3 [71] isolated from the soil of poultry processing plants or Kocuria rizhophila p3-3 [8]. The phylogenetic analysis of the Ker103 strain isolated in this study showed that it is closely related to the Kocuria arsenatis. An actinobacterial strain isolated from the Prosopis laegivata roots, growing on mine tailings, was resistant to a high concentration of arsenic (20 mM) [72]. However, studies showed that the isolates with keratinolytic activity also included Gram-negative bacteria. These belong to the following genera: Pseudomonas, Aeromonas, and Stenotrophomonas. Among Gram-negative keratinolytic isolates, 5 corresponded to the genus Pseudomonas, but only 2 to Aeromonas and 1 to Stenotrophomonas. The ability to hydrolyze keratin substrates has been observed in many Pseudomonas bacteria, among which P. stutzeri K4, isolated from detergent contaminated pond, is notable for its ability to degrade feathers within 5 days. Interestingly, the strain’s crude keratinase preparation was also used for the complete dehairing of goat skin in less than 24 h [73]. Moreover, phylogenetic analysis revealed a relatedness between Ker62 and Aeromonas hydrophila K12, a proteolytic and keratinolytic strain isolated from Brazilian soils of Atlantic Forest and exhibiting high enzyme secretion in minimal media supplemented with feather meal at various temperatures (from 30 °C to 55 °C) [7,10,74]. All the newly isolated strains represent different and equally interesting sources of potential keratinolytic enzymes that could form the basis for the development of biosynthesis of bioactive compounds from waste products, thus linking green chemistry and sustainable waste management together.
As the price of whole-genome sequencing has decreased significantly over the past few years, the analysis and comparison of good-quality bacterial genomes, using open databases and free bioinformatics tools, can provide an alternative for identification methods used in this research (single-marker gene sequencing and MALDI-TOF protein mass fingerprinting) and deliver more precise and reliable results as well as deeper insight into potential enzymatic abilities of keratinolytic strains.
3. Materials and Methods
3.1. Sample Collection
All samples were collected during the spring of 2022 from a rural area on the outskirts of Lodz (Lodzkie voivodeship, Central Poland). Six of them consisted of horsehair gathered during the spring shedding season from two warm-blooded mares (Equus caballus). Both horses were kept on straw and frequently paddocked throughout the year. For each sample, either winter coat hair, fetlock, or gauze soaked in 0.85% NaCl and swabbed through the entire body was taken from each animal. The six soil samples were collected from a small greenhouse, where fallow deer (Dama dama) pelts had been buried approximately 18 months earlier. The soil was dug into 30 cm and 70 cm depths in three places—pelt burial site, and 1 m and 5 m from it (see Table S1). After collection, all samples were stored at 5 °C.
3.2. Isolation of Microorganisms
An amount of 0.5 g of each sample or an entire 5 cm × 5 cm gauze was incubated with 10 mL of sterile 5% glucose water for 24 h at 20 °C and 500 rpm. Serial dilutions with sterile 0.85% NaCl (from 10−1 to 10−6) were prepared for all the samples. Then, 20 μL of each dilution was pipetted onto agar plates with solid Lysogeny Broth (LB) medium (10 g/L tryptone peptone; 10 g/L NaCl; 5 g/L yeast extract; 20 g/L agar) and then 100 U/mL of nystatin (POL-AURA, Morąg, Poland) for the inhibition of fungal growth. The plates were incubated at 10 °C, 20 °C, and 30 °C for 72 h. Every 24 h, the growth of microbial cultures was assessed macroscopically. Single colonies were transferred onto fresh LBP plates using the streaking technique and incubated at temperatures of the original isolation. The process was repeated until pure isolates were obtained. The single microbial colonies were used to prepare glycerol stocks with LB medium (medium/glycerol 1:1 (v/v)) and frozen at −80 °C until further analysis. Example 1 of an equation:
3.3. MALDI-TOF MS—Preliminary Identification of Microorganisms
To discriminate potential pathogenic bacteria, isolates were cultured on LB agar plates for 24 h or 48 h at temperatures corresponding to the isolation conditions. For microbial identification with the MALDI-TOF MS technique and direct smear with the formic acid method, a single colony from each isolate was transferred onto a dedicated steel target plate using a sterile 1 µL inoculation loop. Then, 0.5 μL of 25% formic acid (MERCK, Darmstadt, Germany) was added onto biomass, stirred gently, and left until almost dry. Next, 1 μL of saturated matrix solution (40 mg α-cyano-4-hydroxycinnamic acid (α-CHCA; MERCK, Darmstadt, Germany)) in 1 mL of acetonitrile/ethanol/water 1:1:1 (v/v) with the final trifluoroacetic acid (TFA; MERCK, Darmstadt, Germany) concentration of 3% was added, mixed in, and left to air-dry for 30 min. The dried samples were then analyzed with an AXIMA-iD Plus Confidence MALDI-TOF mass spectrometer (Kratos Analytical Ltd., Manchester, UK and Shimadzu Corporation, Kyoto, Japan). The spectra were collected using Launchpad 2.9 software (Kratos Analytical Ltd., Manchester, UK and Shimadzu Corporation, Kyoto, Japan) in the linear positive ion mode in the mass-to-charge (m/z) ratio range of 2000 to 20,000 Da, with a 50 Hz laser frequency and 90% of laser power. For each sample, a mass spectrum of 200 profiles, each consisting of 5 laser shots, was acquired. The E. coli DH5α (TAKARA BIO Inc., Kusatsu, Japan) cells cultivated overnight on an LB agar plate at 30 °C were used as a control. The SARAMIS Premium 4.11 software (Spectral ARchive and Microbial Identification System; bioMérieux, Craponne, France) was used for comparative analysis of the obtained and reference spectra. Results of the analyses are expressed as confidence scores values [%]. The results obtained in this work are listed in Supplementary Table S1. Only scores ≥ 70% were regarded as sufficient for identification. All potentially pathogenic microorganisms identified among isolates were excluded from further study.
3.4. Screening for Proteolytic and Keratinolytic Enzymatic Activities
3.4.1. Activation of Isolates and Inoculum Preparation
Isolated strains were cultivated in 20 mL of standard LB medium, inoculated with 20 μL of previously prepared and thawed glycerol stocks, for 24 h or 48 h with 140 rpm shaking at 20 °C or 30 °C (depending on the isolation temperature; strains isolated at 10 °C were cultivated at 20 °C to shorten incubation time). After incubation, the optical density (OD) of each culture was measured using a UV-VIS spectrophotometer (Shimadzu UV-1800, Kyoto, Japan) at a 660 nm wavelength. The obtained cultures were then centrifuged for 5 min at 5000 rpm. The pellet was washed with sterile distilled water and centrifuged again. The cells were then resuspended in an adequate volume of distilled water to obtain OD660 = 1 and used as inoculum for a proteolytic activity assay and keratinolytic activity screening.
3.4.2. Proteolytic Activity Assay
For the semi-quantitative assay of proteolytic activity, 2 μL of inoculum (OD660 = 1) was spotted in triplicate on fresh LB agar plates enriched with 0% fat UHT cow’s milk in a 4:1 (v/v) medium/milk ratio. The plates were incubated at 10 °C, 20 °C, or 30 °C and observed after 24 and 48 h. The clear zones around microbial colonies were measured each time and the enzymatic activity index (EAI) for proteolytic activity was calculated using the provided formula:
where
- —the average diameter of clear zones around colonies;
- —the average diameter of colonies.
For comparative analysis of proteolytic activity among the tested strains, it was assumed that EAI values of ≤0.9, ≤1.8, and ≤2.9 correspond to low, medium, and high enzymatic activities towards casein.
3.4.3. Screening for Keratinolytic Activity
For the qualitative screening of keratinolytic activity, strains were cultivated in 250 mL flasks filled with 50 mL of minimal mineral medium (0.5 g/L NH4Cl, 0.5 g/L NaCl, 0.3 g/L K2HPO4, 0.4 g/L KH2PO4, 0.1 g/L MgSO4, 0.1 g/L yeast extract) with the addition of 1% (w/v) keratinolytic activity inducer. Each strain was screened with three types of inducers—chicken feathers (CHFs), dog hair (DH), and horsehair (HH). All keratin substrates were degreased beforehand by 30 min of incubation in a chloroform/ethanol 1:1 (v/v) mixture with intermittent stirring at room temperature and air-dried for 24 h. Keratin inducers were sterilized with liquid media for 15 min at 121 °C. Cultures were inoculated with 1 mL of cells washed and suspended in distilled water with OD660 = 1, and incubated on a rotatory shaker (INFORS HT, Bottmingen, Switzerland) for 7 days at 140 rpm at 10 °C, 20 °C, or 30 °C. After incubation, the post-culture liquids were separated from keratin residues using standard vacuum filtration on a Büchnel funnel with 70 mm Munktell filter paper (Chem-Land, Stargard, Poland). The obtained filtrates were stored at −20 °C. Keratin substrate residues were left to air-dry for at least 24 h. To qualitatively assess the keratinolytic abilities of the isolated strains, the changes in the appearance of post-culture liquids and the degree of keratin substrate degradation were observed macroscopically, graded from 0 to 3. It was assumed that a value of 0.5 indicates only a higher turbidity of culture medium; 1 and 1.5 corresponded to a lesser or greater degree of fragmentation of the horsehairs; 2 indicates a significant decomposition and fragmentation of both used substrates; 2.5 corresponds to a nearly complete decomposition of the feathers, where the only remnants are quills; and 3 means complete degradation of the keratin substrate. The tested strains were compared with the negative control samples (without microbial inoculation).
3.5. Molecular Identification
To identify or confirm the identification of 29 strains, selected based on their keratinolytic and proteolytic activities, the growth rate and MALDI-TOF MS results were chosen for molecular identification via the amplification and sequencing of the 16S rDNA gene V3-V4 fragment with 27F (5′-AGAGTTTGATCMTGGCTCAG-3′) and 785R (5′-CTACCAGGGTATCTAATCC-3′) primers. Genomic DNA (gDNA) was isolated from overnight single colonies using the GeneMATRIX Bacterial & Yeast Genomic DNA Purification Kit (EURx, Gdańsk, Poland). Polymerase chain reaction (PCR) was performed with OptiTaq DNA polymerase in a ready-to-use tiOptiTaq Master Mix (EURx, Poland) solution. The obtained PCR products were purified with the GeneMATRIX Basic DNA Purification Kit (EURx, Poland) and sequenced with Sanger DNA sequencing at Genomed S.A. (Warsaw, Poland). The sequences were then trimmed and compared with reference sequences from the GenBank database using the basic local alignment search tool (BLAST®, NCBI, Bethesda, MD, USA). The sequences obtained in this work were deposited in the GenBank database and their accession numbers are listed in Supplementary Table S2.
3.6. Phylogenetic Analysis
Phylogenetic analysis was based on the most accurate fragments of 16S rDNA region v3-v4, which was proven by [75]. A sequence dataset was created by trimming the v3-v4 region from 16S rDNA genes downloaded from GenBank (Supplementary Table S3). Alignments were performed using the MAFFT v.7 program using default parameters [76]. Phylogenetic analyses were performed in the MEGA-X program using the maximum likelihood (ML) method. Bootstraps analyses were performed using ultrafast bootstrap approximation with 1000 replicates.
4. Conclusions
Sustainable waste management is an important part of pro-environmental practices. The isolation and characterization of keratinolytic microorganisms are necessary for the development of more feasible and greener keratin waste management technologies, which corresponds perfectly with the findings presented in this article. The authors isolated 113 strains from soil and horsehair samples, which were screened for proteolytic and keratinolytic activity. The keratinolytic strains identified in this study belong mainly to the genera Bacillus, Pseudomonas, and Exiguobacterium with Kocuria and Stenotrophomonas. Based on the obtained results, it can be concluded that the soil isolates have higher proteolytic and keratinolytic activities compared to strains from horsehairs. In addition, strains derived from soil can degrade waste substrates rich in α- and β-keratins. There is, however, a marked difference in the degradation of these two substrates, with chicken feathers being more favorable. It is therefore important to look for strains that show activity against different keratin-rich substrates. In further research, a more in-depth genomic, metabolomic, and proteomic characterization of identified keratinolytic strains must be performed for the development of rational and environmentally friendly keratin waste bioprocessing technologies.
Supplementary Materials
The following supporting information can be downloaded at https://www.mdpi.com/article/10.3390/molecules29143380/s1. Table S1: Isolate identification using MALDI-TOF MS and SARAMIS Premium database; Table S2: Taxonomic identification based on v3-v4 16S rDNA fragment analysis with BLASTn® (NCBI); Table S3: The accession numbers of 16S rDNA genes used in the phylogenetic analysis.
Author Contributions
Conceptualization, M.S., I.J. and A.M.B.; Investigation, W.G., M.S. and I.J.; Methodology, M.S. and I.J.; Software, M.S.; Supervision, A.M.B.; Writing—Original Draft Preparation, W.G., M.S., I.J. and A.M.B.; Writing—Review and Editing, A.M.B. All authors have read and agreed to the published version of the manuscript.
Funding
This research was supported by Lodz University of Technology (Poland) as part of the “E2TOP—Excellence in Engineering: Talents in Research with Opportunities Programme” initiative. This article was completed while the second author was the Doctoral Candidate at the Interdisciplinary Doctoral School at the Lodz University of Technology, Poland.
Institutional Review Board Statement
Not applicable.
Informed Consent Statement
Not applicable.
Data Availability Statement
The data are contained within this article.
Conflicts of Interest
The authors declare no conflicts of interest.
References
- Rajabi, M.; Ali, A.; McConnell, M.; Cabral, J. Keratinous Materials: Structures and Functions in Biomedical Applications. Mater. Sci. Eng. C 2020, 110, 110612. [Google Scholar] [CrossRef]
- Kumar Kumawat, T.; Sharma, A.; Sharma, V.; Chandra, S. Keratin Waste: The Biodegradable Polymers. In Keratin; IntechOpen: Rijeka, Croatia, 2018. [Google Scholar]
- Sypka, M.; Jodłowska, I.; Białkowska, A.M. Keratinases as Versatile Enzymatic Tools for Sustainable Development. Biomolecules 2021, 11, 1900. [Google Scholar] [CrossRef] [PubMed]
- Wang, B.; Yang, W.; McKittrick, J.; Meyers, M.A. Keratin: Structure, Mechanical Properties, Occurrence in Biological Organisms, and Efforts at Bioinspiration. Prog. Mater. Sci. 2016, 76, 229–318. [Google Scholar] [CrossRef]
- Perța-Crișan, S.; Ursachi, C.; Ștefan; Gavrilaș, S.; Oancea, F.; Munteanu, F.D. Closing the Loop with Keratin-Rich Fibrous Materials. Polymers 2021, 13, 1896. [Google Scholar] [CrossRef] [PubMed]
- Sinkiewicz, I.; Staroszczyk, H.; Śliwińska, A. Solubilization of Keratins and Functional Properties of Their Isolates and Hydrolysates. J. Food Biochem. 2018, 42, e12494. [Google Scholar] [CrossRef]
- Bach, E.; Lopes, F.C.; Brandelli, A. Biodegradation of α and β-Keratins by Gram-Negative Bacteria. Int. Biodeterior. Biodegrad. 2015, 104, 136–141. [Google Scholar] [CrossRef]
- Łaba, W.; Żarowska, B.; Chorążyk, D.; Pudło, A.; Piegza, M.; Kancelista, A.; Kopeć, W. New Keratinolytic Bacteria in Valorization of Chicken Feather Waste. AMB Express 2018, 8, 9. [Google Scholar] [CrossRef]
- Vidmar, B.; Vodovnik, M. Microbial Keratinases: Enzymes with Promising Biotechnological Applications. Food Technol. Biotechnol. 2018, 56, 312–328. [Google Scholar] [CrossRef] [PubMed]
- Bach, E.; Cannavan, F.S.; Duarte, F.R.S.; Taffarel, J.A.S.; Tsai, S.M.; Brandelli, A. Characterization of Feather-Degrading Bacteria from Brazilian Soils. Int. Biodeterior. Biodegrad. 2011, 65, 102–107. [Google Scholar] [CrossRef]
- Brandelli, A.; Sala, L.; Kalil, S.J. Microbial Enzymes for Bioconversion of Poultry Waste into Added-Value Products. Food Res. Int. 2015, 73, 3–12. [Google Scholar] [CrossRef]
- Martín-González, D.; Bordel, S.; Santos-Beneit, F. Characterization of the Keratinolytic Activity of Three Streptomyces Strains and Impact of Their Co-Cultivation on This Activity. Microorganisms 2023, 11, 1109. [Google Scholar] [CrossRef] [PubMed]
- Queiroga, A.C.; Pintado, M.E.; Malcata, F.X. Search for Novel Proteolytic Enzymes Aimed at Textile and Agro-Industrial Applications: An Overview of Current and Novel Approaches. Biocatal. Biotransform. 2012, 30, 154–169. [Google Scholar] [CrossRef]
- Pelletier, M.; Draper, J. Characterization and Identification of Bacterial Flora from Infected Equine Hooves. Int. J. Vet. Sci. Res. 2022, 8, 050–056. [Google Scholar] [CrossRef]
- Tuohy, J.M.; Mueller-Spitz, S.R.; Albert, C.M.; Scholz-Ng, S.E.; Wall, M.E.; Noutsios, G.T.; Gutierrez, A.J.; Sandrin, T.R. MALDI-TOF MS Affords Discrimination of Deinococcus Aquaticus Isolates Obtained From Diverse Biofilm Habitats. Front. Microbiol. 2018, 9, 2442. [Google Scholar] [CrossRef] [PubMed]
- Jia Khor, M.; Broda, A.; Kostrzewa, M.; Drobniewski, F.; Larrouy-Maumus, G. An Improved Method for Rapid Detection of Mycobacterium Abscessus Complex Based on Species-Specific Lipid Fingerprint by Routine MALDI-TOF. Front. Chem. 2021, 9, 715890. [Google Scholar] [CrossRef] [PubMed]
- Vidal, L.M.R.; Venas, T.M.; Gonçalves, A.R.P.; Mattsson, H.K.; Silva, R.V.P.; Nóbrega, M.S.; Azevedo, G.P.R.; Garcia, G.D.; Tschoeke, D.A.; Vieira, V.V.; et al. Rapid Screening of Marine Bacterial Symbionts Using MALDI-TOF MS. Arch. Microbiol. 2020, 202, 2329–2336. [Google Scholar] [CrossRef] [PubMed]
- Fernández-Bravo, A.; Figueras, M.J. An Update on the Genus Aeromonas: Taxonomy, Epidemiology, and Pathogenicity. Microorganisms 2020, 8, 129. [Google Scholar] [CrossRef]
- Afridi, M.S.; Van Hamme, J.d.; Bundschuh, J.; Sumaira; Khan, M.N.; Salam, A.; Waqar, M.; Munis, M.F.H.; Chaudhary, H.J. Biotechnological Approaches in Agriculture and Environmental Management—Bacterium Kocuria Rhizophila 14ASP as Heavy Metal and Salt- Tolerant Plant Growth- Promoting Strain. Biologia 2021, 76, 3091–3105. [Google Scholar] [CrossRef]
- Pons, I.; Scieur, N.; Dhondt, L.; Renard, M.-E.; Renoz, F.; Hance, T. Pervasiveness of the Symbiont Serratia Symbiotica in the Aphid Natural Environment: Distribution, Diversity and Evolution at a Multitrophic Level. FEMS Microbiol. Ecol. 2022, 98, fiac012. [Google Scholar] [CrossRef]
- Chiellini, C.; Lombardo, K.; Mocali, S.; Miceli, E.; Fani, R. Pseudomonas Strains Isolated from Different Environmental Niches Exhibit Different Antagonistic Ability. Ethol. Ecol. Evol. 2019, 31, 399–420. [Google Scholar] [CrossRef]
- Alyousif, N.A. Distribution, Occurrence and Molecular Characterization of Bacillus Related Species Isolated from Different Soil in Basrah Province, Iraq. Biodiversitas 2022, 23, 679–686. [Google Scholar] [CrossRef]
- Strompfová, V.; Štempelová, L. Composition and Diversity of 16S RRNA Based Skin Bacterial Microbiome in Healthy Horses. Vet. Res. Commun. 2024. [Google Scholar] [CrossRef]
- Kamus, L.J.; Theoret, C.; Costa, M.C. Use of next Generation Sequencing to Investigate the Microbiota of Experimentally Induced Wounds and the Effect of Bandaging in Horses. PLoS ONE 2018, 13, e0206989. [Google Scholar] [CrossRef] [PubMed]
- O’Shaughnessy-Hunter, L.C.; Yu, A.; Rousseau, J.D.; Foster, R.A.; Weese, J.S. Longitudinal Study of the Cutaneous Microbiota of Healthy Horses. Vet. Dermatol. 2021, 32, 467. [Google Scholar] [CrossRef]
- Meena, V.S.; Maurya, B.R.; Meena, S.K.; Meena, R.K.; Kumar, A.; Verma, J.P.; Singh, N.P. Can Bacillus Species Enhance Nutrient Availability in Agricultural Soils? In Bacilli and Agrobiotechnology; Springer International Publishing: Cham, Switzerland, 2016; pp. 367–395. [Google Scholar]
- Chaudhary, P.; Xu, M.; Ahamad, L.; Chaudhary, A.; Kumar, G.; Adeleke, B.S.; Verma, K.K.; Hu, D.-M.; Širić, I.; Kumar, P.; et al. Application of Synthetic Consortia for Improvement of Soil Fertility, Pollution Remediation, and Agricultural Productivity: A Review. Agronomy 2023, 13, 643. [Google Scholar] [CrossRef]
- Paśmionka, I.B.; Bulski, K.; Boligłowa, E. The Participation of Microbiota in the Transformation of Nitrogen Compounds in the Soil—A Review. Agronomy 2021, 11, 977. [Google Scholar] [CrossRef]
- Karmakar, D.; Magotra, S.; Negi, R.; Kumar, S.; Rustagi, S.; Singh, S.; Rai, A.K.; Kour, D.; Yadav, A.N. Bacillus Species for Sustainable Management of Heavy Metals in Soil: Current Research and Future Challenges. J. Appl. Biol. Biotechnol. 2024, 12, 22–35. [Google Scholar] [CrossRef]
- Baranova, M.N.; Kudzhaev, A.M.; Mokrushina, Y.A.; Babenko, V.V.; Kornienko, M.A.; Malakhova, M.V.; Yudin, V.G.; Rubtsova, M.P.; Zalevsky, A.; Belozerova, O.A.; et al. Deep Functional Profiling of Wild Animal Microbiomes Reveals Probiotic Bacillus Pumilus Strains with a Common Biosynthetic Fingerprint. Int. J. Mol. Sci. 2022, 23, 1168. [Google Scholar] [CrossRef]
- Tiwari, S.; Prasad, V.; Lata, C. Bacillus: Plant Growth Promoting Bacteria for Sustainable Agriculture and Environment. In New and Future Developments in Microbial Biotechnology and Bioengineering; Elsevier: Amsterdam, The Netherlands, 2019; pp. 43–55. [Google Scholar]
- Schwabe, R.; Dittrich, C.; Kadner, J.; Rudi Senges, C.H.; Bandow, J.E.; Tischler, D.; Schlömann, M.; Levicán, G.; Wiche, O. Secondary Metabolites Released by the Rhizosphere Bacteria Arthrobacter Oxydans and Kocuria Rosea Enhance Plant Availability and Soil–Plant Transfer of Germanium (Ge) and Rare Earth Elements (REEs). Chemosphere 2021, 285, 131466. [Google Scholar] [CrossRef] [PubMed]
- Williams, D.J.; Grimont, P.A.D.; Cazares, A.; Grimont, F.; Ageron, E.; Pettigrew, K.A.; Cazares, D.; Njamkepo, E.; Weill, F.-X.; Heinz, E.; et al. The Genus Serratia Revisited by Genomics. Nat. Commun. 2022, 13, 5195. [Google Scholar] [CrossRef] [PubMed]
- Ehling-Schulz, M.; Lereclus, D.; Koehler, T.M. The Bacillus Cereus Group: Bacillus Species with Pathogenic Potential. Microbiol. Spectr. 2019, 7, GPP3-0032-2018. [Google Scholar] [CrossRef] [PubMed]
- Jurado-Martín, I.; Sainz-Mejías, M.; McClean, S. Pseudomonas Aeruginosa: An Audacious Pathogen with an Adaptable Arsenal of Virulence Factors. Int. J. Mol. Sci. 2021, 22, 3128. [Google Scholar] [CrossRef] [PubMed]
- Carrasco, G.; de Dios Caballero, J.; Garrido, N.; Valdezate, S.; Cantón, R.; Sáez-Nieto, J.A. Shortcomings of the Commercial MALDI-TOF MS Database and Use of MLSA as an Arbiter in the Identification of Nocardia Species. Front. Microbiol. 2016, 7, 542. [Google Scholar] [CrossRef] [PubMed]
- Emami, K.; Nelson, A.; Hack, E.; Zhang, J.; Green, D.H.; Caldwell, G.S.; Mesbahi, E. MALDI-TOF Mass Spectrometry Discriminates Known Species and Marine Environmental Isolates of Pseudoalteromonas. Front. Microbiol. 2016, 7, 104. [Google Scholar] [CrossRef] [PubMed]
- Garrigos, T.; Neuwirth, C.; Chapuis, A.; Bador, J.; Amoureux, L.; Andre, E.; Barbier, E.; Caillon, J.; Cardot-Martin, E.; Cattoir, V.; et al. Development of a Database for the Rapid and Accurate Routine Identification of Achromobacter Species by Matrix-Assisted Laser Desorption/Ionization–Time-of-Flight Mass Spectrometry (MALDI-TOF MS). Clin. Microbiol. Infect. 2021, 27, 126.e1–126.e5. [Google Scholar] [CrossRef] [PubMed]
- Seuylemezian, A.; Aronson, H.S.; Tan, J.; Lin, M.; Schubert, W.; Vaishampayan, P. Development of a Custom MALDI-TOF MS Database for Species-Level Identification of Bacterial Isolates Collected From Spacecraft and Associated Surfaces. Front. Microbiol. 2018, 9, 780. [Google Scholar] [CrossRef] [PubMed]
- Rios, P.; Bezus, B.; Cavalitto, S.; Cavello, I. Production and Characterization of a New Detergent-Stable Keratinase Expressed by Pedobacter Sp. 3.14.7, a Novel Antarctic Psychrotolerant Keratin-Degrading Bacterium. J. Genet. Eng. Biotechnol. 2022, 20, 81. [Google Scholar] [CrossRef] [PubMed]
- Jagadeesan, Y.; Meenakshisundaram, S.; Saravanan, V.; Balaiah, A. Sustainable Production, Biochemical and Molecular Characterization of Thermo-and-Solvent Stable Alkaline Serine Keratinase from Novel Bacillus Pumilus AR57 for Promising Poultry Solid Waste Management. Int. J. Biol. Macromol. 2020, 163, 135–146. [Google Scholar] [CrossRef]
- Nnolim, N.E.; Okoh, A.I.; Nwodo, U.U. Proteolytic Bacteria Isolated from Agro-Waste Dumpsites Produced Keratinolytic Enzymes. Biotechnol. Rep. 2020, 27, e00483. [Google Scholar] [CrossRef]
- Akram, F.; ul Haq, I.; Hayat, A.K.; Ahmed, Z.; Jabbar, Z.; Baig, I.M.; Akram, R. Keratinolytic Enzyme from a Thermotolerant Isolate Bacillus Sp. NDS-10: An Efficient Green Biocatalyst for Poultry Waste Management, Laundry and Hide-Dehairing Applications. Waste Biomass Valorization 2021, 12, 5001–5018. [Google Scholar] [CrossRef]
- Sharma, I.; Kango, N. Production and Characterization of Keratinase by Ochrobactrum Intermedium for Feather Keratin Utilization. Int. J. Biol. Macromol. 2021, 166, 1046–1056. [Google Scholar] [CrossRef] [PubMed]
- González, V.; Vargas-Straube, M.J.; Beys-da-Silva, W.O.; Santi, L.; Valencia, P.; Beltrametti, F.; Cámara, B. Enzyme Bioprospection of Marine-Derived Actinobacteria from the Chilean Coast and New Insight in the Mechanism of Keratin Degradation in Streptomyces Sp. G11C. Mar. Drugs 2020, 18, 537. [Google Scholar] [CrossRef] [PubMed]
- Duffeck, C.E.; de Menezes, C.L.A.; Boscolo, M.; da Silva, R.; Gomes, E.; da Silva, R.R. Keratinases from Coriolopsis Byrsina as an Alternative for Feather Degradation: Applications for Cloth Cleaning Based on Commercial Detergent Compatibility and for the Production of Collagen Hydrolysate. Biotechnol. Lett. 2020, 42, 2403–2412. [Google Scholar] [CrossRef] [PubMed]
- Vranova, V.; Rejsek, K.; Formanek, P. Proteolytic Activity in Soil: A Review. Appl. Soil Ecol. 2013, 70, 23–32. [Google Scholar] [CrossRef]
- Greenfield, L.M.; Puissant, J.; Jones, D.L. Synthesis of Methods Used to Assess Soil Protease Activity. Soil Biol. Biochem. 2021, 158, 108277. [Google Scholar] [CrossRef]
- Greenfield, L.M.; Hill, P.W.; Seaton, F.M.; Paterson, E.; Baggs, E.M.; Jones, D.L. Is Soluble Protein Mineralisation and Protease Activity in Soil Regulated by Supply or Demand? Soil Biol. Biochem. 2020, 150, 108007. [Google Scholar] [CrossRef]
- Khatoon, H.; Solanki, P.; Narayan, M.; Tewari, L.; Rai, J. Role of Microbes in Organic Carbon Decomposition and Maintenance of Soil Ecosystem. Int. J. Chem. Stud. 2017, 5, 1648–1656. [Google Scholar]
- Figaj, D.; Ambroziak, P.; Przepiora, T.; Skorko-Glonek, J. The Role of Proteases in the Virulence of Plant Pathogenic Bacteria. Int. J. Mol. Sci. 2019, 20, 672. [Google Scholar] [CrossRef] [PubMed]
- Skaljac, M.; Vogel, H.; Wielsch, N.; Mihajlovic, S.; Vilcinskas, A. Transmission of a Protease-Secreting Bacterial Symbiont among Pea Aphids via Host Plants. Front. Physiol. 2019, 10, 438. [Google Scholar] [CrossRef]
- Susič, N.; Janežič, S.; Rupnik, M.; Stare, B.G. Whole Genome Sequencing and Comparative Genomics of Two Nematicidal Bacillus Strains Reveals a Wide Range of Possible Virulence Factors. G3 Genes Genomes Genet. 2020, 10, 881–890. [Google Scholar] [CrossRef]
- Hidayati, N.; Nurrahman, N.; Fuad, H.; Munandar, H.; Zilda, D.S.; Ernanto, A.R.; Samiasih, A.; Oedjijono, O.; Ethica, S.N. Bacillus Tequilensis Isolated from Fermented Intestine of Holothuria Scabra Produces Fibrinolytic Protease with Thrombolysis Activity. IOP Conf. Ser. Earth Environ. Sci. 2021, 707, 012008. [Google Scholar] [CrossRef]
- Hossain, T.J.; Das, M.; Ali, F.; Chowdhury, S.I.; Zedny, S.A. Substrate Preferences, Phylogenetic and Biochemical Properties of Proteolytic Bacteria Present in the Digestive Tract of Nile Tilapia (Oreochromis niloticus). AIMS Microbiol. 2021, 7, 528–545. [Google Scholar] [CrossRef]
- Fang, Z.; Zhang, J.; Liu, B.; Du, G.; Chen, J. Biochemical Characterization of Three Keratinolytic Enzymes from Stenotrophomonas Maltophilia BBE11-1 for Biodegrading Keratin Wastes. Int. Biodeterior. Biodegrad. 2013, 82, 166–172. [Google Scholar] [CrossRef]
- Wu, W.-L.; Chen, M.-Y.; Tu, I.-F.; Lin, Y.-C.; EswarKumar, N.; Chen, M.-Y.; Ho, M.-C.; Wu, S.-H. The Discovery of Novel Heat-Stable Keratinases from Meiothermus Taiwanensis WR-220 and Other Extremophiles. Sci. Rep. 2017, 7, 4658. [Google Scholar] [CrossRef]
- Kang, E.; Jin, H.; La, J.W.; Sung, J.; Park, S.; Kim, W.; Lee, D. Identification of Keratinases from Fervidobacterium islandicum AW-1 Using Dynamic Gene Expression Profiling. Microb. Biotechnol. 2020, 13, 442–457. [Google Scholar] [CrossRef] [PubMed]
- Su, C.; Gong, J.-S.; Qin, J.; Li, H.; Li, H.; Xu, Z.-H.; Shi, J.-S. The Tale of a Versatile Enzyme: Molecular Insights into Keratinase for Its Industrial Dissemination. Biotechnol. Adv. 2020, 45, 107655. [Google Scholar] [CrossRef]
- Bohacz, J.; Korniłłowicz-Kowalska, T. Fungal Diversity and Keratinolytic Activity of Fungi from Lignocellulosic Composts with Chicken Feathers. Process Biochem. 2019, 80, 119–128. [Google Scholar] [CrossRef]
- Liu, Y.; Du, J.; Lai, Q.; Zeng, R.; Ye, D.; Xu, J.; Shao, Z. Proposal of Nine Novel Species of the Bacillus Cereus Group. Int. J. Syst. Evol. Microbiol. 2017, 67, 2499–2508. [Google Scholar] [CrossRef] [PubMed]
- Gumilar, J.; Triatmojo, S.; Mira Yusiati, L.; Pertiwiningrum, A. Isolation, Identification and Dehairing Activity of Indonesian Native Keratinolytic Bacteria Exiguobacterium Sp. DG1. J. Biotechnol. 2015, 12, 41–48. [Google Scholar]
- Emon, T.H.; Hakim, A.; Chakraborthy, D.; Bhuyan, F.R.; Iqbal, A.; Hasan, M.; Aunkor, T.H.; Azad, A.K. Kinetics, Detergent Compatibility and Feather-Degrading Capability of Alkaline Protease from Bacillus Subtilis AKAL7 and Exiguobacterium Indicum AKAL11 Produced with Fermentation of Organic Municipal Solid Wastes. J. Environ. Sci. Health Part A 2020, 55, 1339–1348. [Google Scholar] [CrossRef]
- Martín-González, D.; Bordel, S.; Solis, S.; Gutierrez-Merino, J.; Santos-Beneit, F. Characterization of Bacillus Strains from Natural Honeybee Products with High Keratinolytic Activity and Antimicrobial Potential. Microorganisms 2023, 11, 456. [Google Scholar] [CrossRef] [PubMed]
- Moridshahi, R.; Bahreini, M.; Sharifmoghaddam, M.; Asoodeh, A. Biochemical Characterization of an Alkaline Surfactant-Stable Keratinase from a New Keratinase Producer, Bacillus Zhangzhouensis. Extremophiles 2020, 24, 693–704. [Google Scholar] [CrossRef] [PubMed]
- Abdel-Fattah, A.M.; El-Gamal, M.S.; Ismail, S.A.; Emran, M.A.; Hashem, A.M. Biodegradation of Feather Waste by Keratinase Produced from Newly Isolated Bacillus Licheniformis ALW1. J. Genet. Eng. Biotechnol. 2018, 16, 311–318. [Google Scholar] [CrossRef] [PubMed]
- Zhang, R.-X.; Wu, Z.-W.; Cui, H.-Y.; Chai, Y.-N.; Hua, C.-W.; Wang, P.; Li, L.; Yang, T.-Y. Production of Surfactant-Stable Keratinase from Bacillus Cereus YQ15 and Its Application as Detergent Additive. BMC Biotechnol. 2022, 22, 26. [Google Scholar] [CrossRef]
- Devi, S.; Chauhan, A.; Bishist, R.; Sankhyan, N.; Rana, K.; Sharma, N. Production, Partial Purification and Efficacy of Keratinase from Bacillus Halotolerans L2EN1 Isolated from the Poultry Farm of Himachal Pradesh as a Potential Laundry Additive. Biocatal. Biotransform. 2023, 41, 222–242. [Google Scholar] [CrossRef]
- Bernal, C.; Vidal, L.; Valdivieso, E.; Coello, N. Keratinolytic Activity of Kocuria Rosea. World J. Microbiol. Biotechnol. 2003, 19, 255–261. [Google Scholar] [CrossRef]
- Coello, N.; Vidal, L. Kocuria Rosea as a New Feather Degrading Bacteria. In Applied Microbiology; Kluwer Academic Publishers: Dordrecht, The Netherlands, 2001; pp. 165–175. [Google Scholar] [CrossRef]
- Bernal, C.; Cairó, J.; Coello, N. Purification and Characterization of a Novel Exocellular Keratinase from Kocuria Rosea. Enzyme Microb. Technol. 2006, 38, 49–54. [Google Scholar] [CrossRef]
- Román-Ponce, B.; Wang, D.; Soledad Vásquez-Murrieta, M.; Feng Chen, W.; Estrada-de los Santos, P.; Hua Sui, X.; Tao Wang, E. Kocuria Arsenatis Sp. Nov., an Arsenic-Resistant Endophytic Actinobacterium Associated with Prosopis Laegivata Grown on High-Arsenic-Polluted Mine Tailing. Int. J. Syst. Evol. Microbiol. 2016, 66, 1027–1033. [Google Scholar] [CrossRef] [PubMed]
- Chaturvedi, V.; Bhange, K.; Bhatt, R.; Verma, P. Production of Kertinases Using Chicken Feathers as Substrate by a Novel Multifunctional Strain of Pseudomonas Stutzeri and Its Dehairing Application. Biocatal. Agric. Biotechnol. 2014, 3, 167–174. [Google Scholar] [CrossRef]
- Bach, E.; Daroit, D.J.; Corrêa, A.P.F.; Brandelli, A. Production and Properties of Keratinolytic Proteases from Three Novel Gram-Negative Feather-Degrading Bacteria Isolated from Brazilian Soils. Biodegradation 2011, 22, 1191–1201. [Google Scholar] [CrossRef]
- Thijs, S.; Op De Beeck, M.; Beckers, B.; Truyens, S.; Stevens, V.; Van Hamme, J.D.; Weyens, N.; Vangronsveld, J. Comparative Evaluation of Four Bacteria-Specific Primer Pairs for 16S RRNA Gene Surveys. Front. Microbiol. 2017, 8, 494. [Google Scholar] [CrossRef] [PubMed]
- Katoh, K.; Rozewicki, J.; Yamada, K.D. MAFFT Online Service: Multiple Sequence Alignment, Interactive Sequence Choice and Visualization. Brief. Bioinform. 2019, 20, 1160–1166. [Google Scholar] [CrossRef] [PubMed]
Disclaimer/Publisher’s Note: The statements, opinions and data contained in all publications are solely those of the individual author(s) and contributor(s) and not of MDPI and/or the editor(s). MDPI and/or the editor(s) disclaim responsibility for any injury to people or property resulting from any ideas, methods, instructions or products referred to in the content. |
© 2024 by the authors. Licensee MDPI, Basel, Switzerland. This article is an open access article distributed under the terms and conditions of the Creative Commons Attribution (CC BY) license (https://creativecommons.org/licenses/by/4.0/).